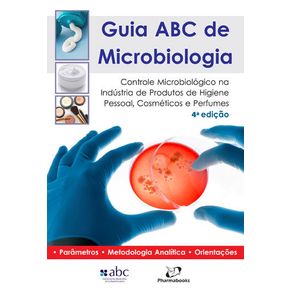
787189_ampliada.jpg 787189_ampliada.jpg

Calcule o frete:
Para envios internacionais, simule o frete no carrinho de compras.
Sinopse
Ficha Técnica
Especificações
| ISBN | 9788589731652 |
|---|---|
| Subtítulo | CONTROLE MICROBIOLOGICO NA INDUSTRIA DE PRODUTOS DE HIGIENE PESSOAL, COSMETICOS E PERFUMES |
| Pré venda | Não |
| Peso | 281g |
| Autor para link | ASSOCIAÇAO BRASILEIRA DE COSMETOLOGIA ABC |
| Livro disponível - pronta entrega | Não |
| Idioma | Português |
| Tipo item | Livro Nacional |
| Número de páginas | 180 |
| Número da edição | 4ªEDIÇÃO - 2014 |
| Código Interno | 787189 |
| Código de barras | 9788589731652 |
| Acabamento | BROCHURA |
| Autor | ASSOCIAÇAO BRASILEIRA DE COSMETOLOGIA ABC |
| Editora | PHARMABOOKS ** |
| Sob encomenda | Não |